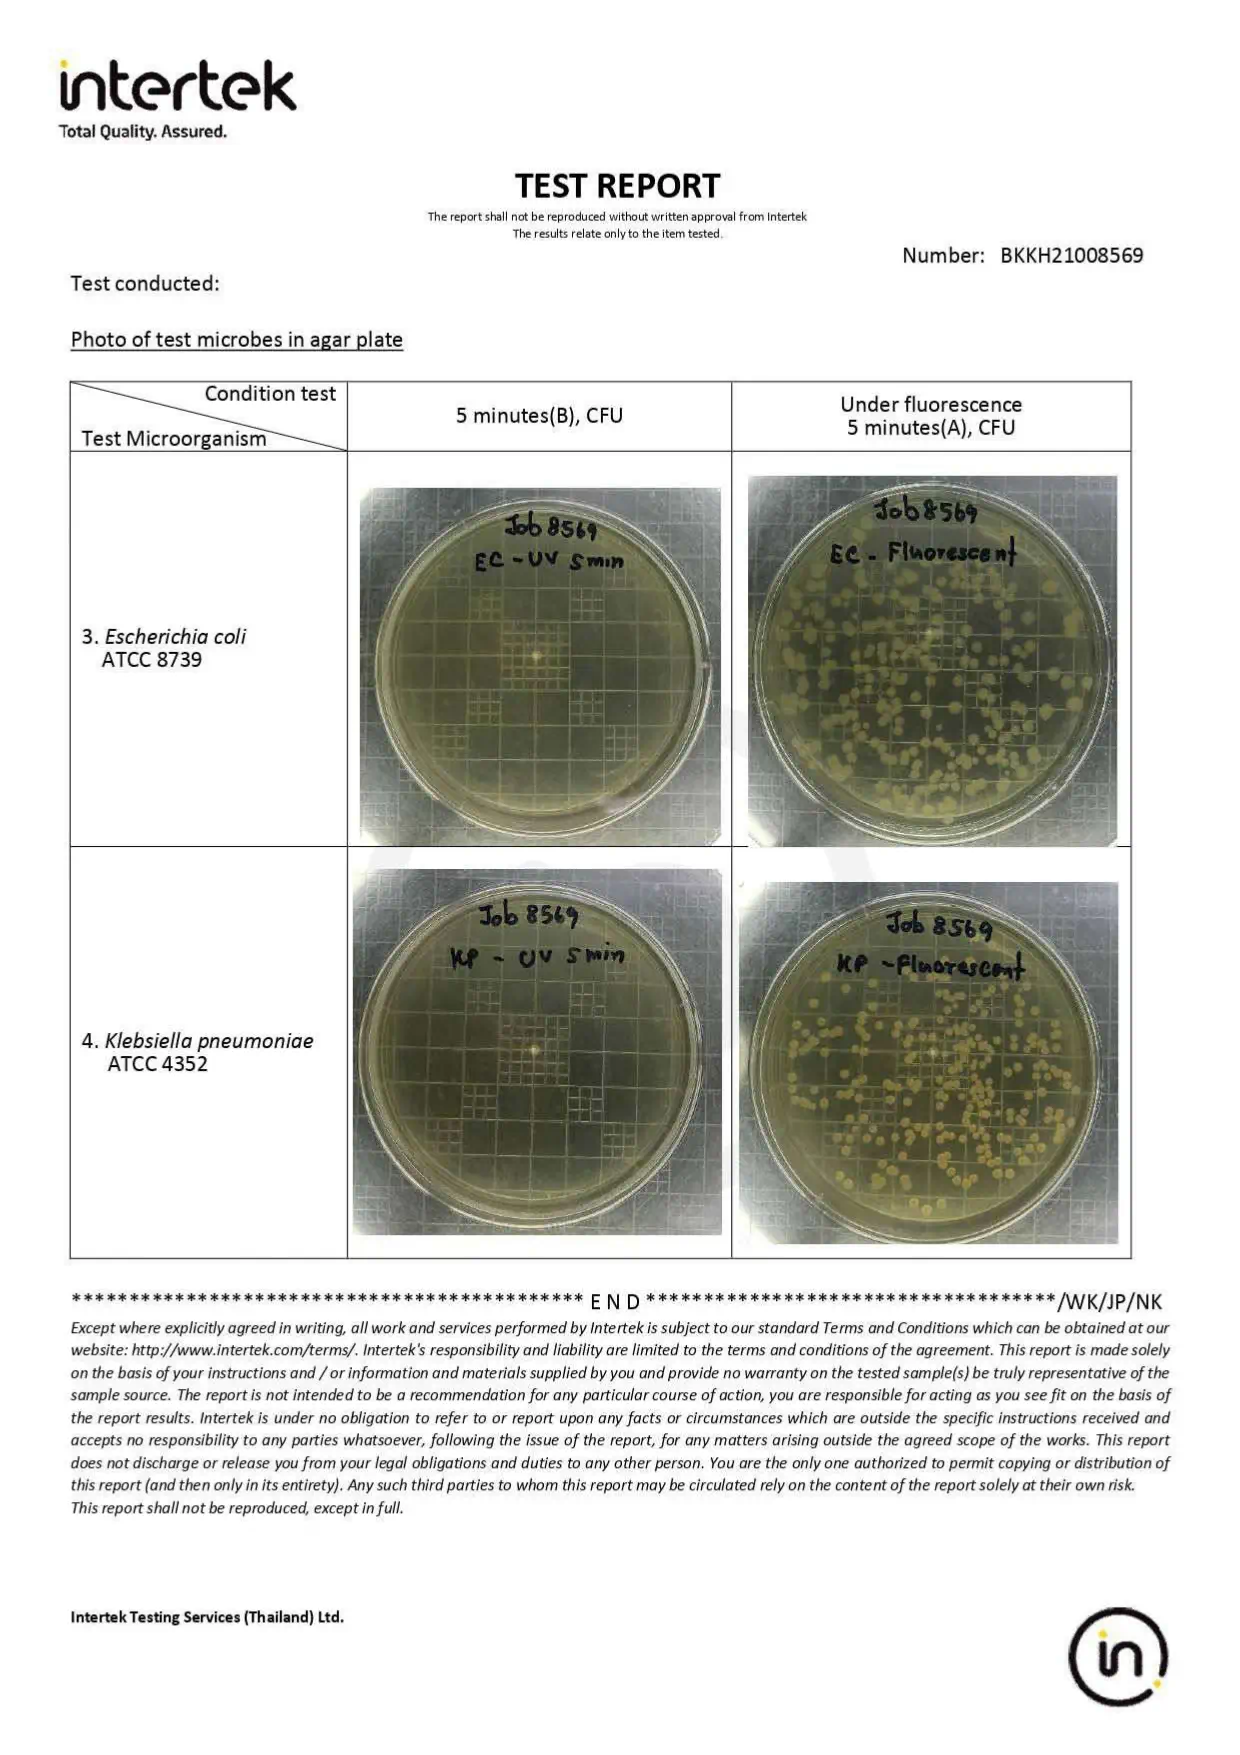

เครื่องอบโอโซน Master Ozone หรือเครื่องโอโซนสำหรับฆ่าเชื้อและกำจัดกลิ่น ด้วยเทคโนโลยี เครื่องผลิตโอโซน ozone generator ที่ช่วย อบโอโซนห้อง และ อบโอโซนรถยนต์ ได้อย่างมีประสิทธิภาพ กำจัดเชื้อโรคและกลิ่นไม่พึงประสงค์ ทำให้อากาศสะอาด สดชื่น เหมาะสำหรับใช้ในบ้าน สำนักงาน และ เครื่องทำโอโซน เพื่อสุขอนามัยที่ดีขึ้น
หมวดหมู่ : เครื่องผลิตโอโซน ,  เครื่องฟอกอากาศ ,  สินค้าแนะนำ , 
แบรนด์ : Master Ozone Generator
Share






เครื่องอบโอโซน หรือที่เรียกว่า เครื่องกำเนิดโอโซน ทำหน้าที่ผลิตก๊าซโอโซน (O) ซึ่งเป็นสารออกซิไดซ์ที่มีประสิทธิภาพสูง สามารถฆ่าเชื้อแบคทีเรีย ไวรัส และเชื้อราต่างๆ ได้อย่างรวดเร็ว โอโซน ฆ่า เชื้อ ได้ดีกว่าวิธีการทำความสะอาดทั่วไป เนื่องจากสามารถแทรกซึมเข้าไปในอากาศ พื้นผิว และจุดที่เข้าถึงยากได้
ปัจจุบันมีการพัฒนา เครื่องทำโอโซน ให้มีประสิทธิภาพมากขึ้น สามารถใช้งานได้หลากหลายทั้งในบ้านพักอาศัย อาคารสำนักงาน รวมถึงการกำจัดกลิ่นไม่พึงประสงค์ในพื้นที่ปิด นอกจากนี้ยังมี เครื่องozone รุ่นพกพาที่ออกแบบมาเพื่อความสะดวกในการใช้งานในพื้นที่เล็กและเฉพาะจุด
สำหรับผู้ที่พักอาศัยในอาคารชุด การเลือกใช้บริการ อบ โอโซนคอนโด ก็เป็นอีกหนึ่งวิธีที่ได้รับความนิยม เนื่องจากสามารถช่วยกำจัดเชื้อโรคและกลิ่นไม่พึงประสงค์ได้อย่างทั่วถึงในพื้นที่ห้องพักขนาดจำกัด
นอกจากนี้ ในภาคยานยนต์ยังมีการใช้ เครื่องอบโอโซนรถยนต์ เพื่อฆ่าเชื้อ และกำจัดกลิ่นอับในห้องโดยสาร ทำให้รถยนต์สะอาด สดชื่น และปลอดภัยต่อผู้ขับขี่และผู้โดยสารมากยิ่งขึ้น

เปลี่ยนอากาศอับชื้นและกลิ่นไม่พึงประสงค์ในบ้านหรือรถของคุณ ให้กลับมาสะอาด สดชื่น และน่าอยู่ ด้วย เครื่องโอโซนกำจัดกลิ่น เทคโนโลยีล้ำสมัยที่ช่วยขจัดกลิ่นบุหรี่ กลิ่นอับ และกลิ่นอาหารได้อย่างมีประสิทธิภาพ เพราะ เครื่องอบโอโซน มีคุณสมบัติที่พร้อมยับยั้งเชื้อโรคและแบคทีเรียในอากาศ นอกจากนี้ยังสามารถใช้เป็น เครื่องฆ่าเชื้อโอโซน ที่ช่วยกำจัดไวรัสและเชื้อโรคต่าง ๆ ได้อย่างมีประสิทธิภาพ เหมาะสำหรับผู้ที่ต้องการสร้างสภาพแวดล้อมที่ปลอดภัยและสุขอนามัยที่ดีภายในบ้านหรือสำนักงาน
สำหรับพื้นที่จอดรถหรือโรงรถที่มักมีกลิ่นอับและเชื้อโรคสะสม การเลือกใช้ เครื่องพ่นโอโซนโรงรถ ก็เป็นอีกหนึ่งทางออกที่ช่วยทำให้อากาศสะอาด ปลอดภัย และลดการสะสมของเชื้อแบคทีเรียและเชื้อราที่อาจก่อให้เกิดปัญหาสุขภาพในระยะยาว
ในขณะเดียวกัน สำหรับภาคยานยนต์หรือธุรกิจบริการดูแลรถ การเลือกใช้ เครื่องอบโอโซนรถยนต์ คาร์แคร์ ก็เป็นอีกหนึ่งโซลูชันที่ได้รับความนิยม เพราะสามารถช่วยกำจัดกลิ่นอับ กลิ่นบุหรี่ และฆ่าเชื้อโรคภายในห้องโดยสารได้อย่างมีประสิทธิภาพ สร้างความมั่นใจให้กับทั้งผู้ให้บริการและลูกค้าที่มาใช้บริการ ใช้งานง่าย ปลอดภัยต่อคนและสัตว์เลี้ยง คืนอากาศบริสุทธิ์ให้คุณและครอบครัว
เพียงเปิดเครื่อง ทิ้งไว้ 30 นาที – คุณจะสัมผัสได้ถึงความเปลี่ยนแปลงที่ชัดเจนในทันที!

ในแอร์และเฟอร์นิเจอร์ภายในบ้านหรือที่พักอาศัย มักมีการสะสมของสารก่อภูมิแพ้และเชื้อราโดยไม่รู้ตัว ทั้งความชื้น หรืออากาศถ่ายเทไม่สะดวก เชื้อราและสารก่อภูมิแพ้เหล่านี้เป็นสาเหตุสำคัญของโรคภูมิแพ้ หอบหืด และโรคระบบทางเดินหายใจ โดยเฉพาะในเด็กเล็กและผู้สูงอายุ การใช้เทคโนโลยี โอโซนฆ่าเชื้อโรค จึงเป็นอีกหนึ่งวิธีที่ช่วยกำจัดเชื้อรา แบคทีเรีย และสารก่อภูมิแพ้ได้อย่างล้ำลึก โอโซนสามารถแทรกซึมเข้าไปในทุกซอกมุม ทั้งบนพื้นผิว เฟอร์นิเจอร์ รวมถึงระบบแอร์ภายในบ้าน ทำให้สภาพแวดล้อมสะอาดและปลอดภัยยิ่งขึ้น เหมาะสำหรับผู้ที่ต้องการลดความเสี่ยงจากโรคภูมิแพ้และสร้างบรรยากาศที่ดีต่อสุขภาพของทุกคนในครอบครัว
ทางออกที่ได้ผล:
การใช้ เครื่องโอโซนฆ่าเชื้อ Master Ozone Generator เป็นอีกหนึ่งทางเลือกที่ทันสมัยและปลอดภัย เครื่องนี้สามารถปล่อยโอโซนเข้าไปกำจัดเชื้อรา แบคทีเรีย และสารก่อภูมิแพ้ตามจุดต่าง ๆ ทั้งในแอร์ เฟอร์นิเจอร์ หรือบริเวณที่อากาศไม่ถ่ายเท ช่วยลดปัญหาสุขภาพและสร้างอากาศสะอาดสดชื่นภายในบ้าน
ข้อดีของการใช้ Master Ozone Generator:
หากคุณต้องการอากาศที่บริสุทธิ์และสุขภาพที่ดีสำหรับทุกคนในครอบครัว ให้ เครื่องโอโซนฆ่าเชื้อ Master Ozone Generator ดูแลคุณในทุกพื้นที่ของบ้าน

ในปัจจุบัน เชื้อโรค แบคทีเรีย และไวรัสสามารถปะปนอยู่ในอากาศรอบตัวเราโดยไม่รู้ตัว ซึ่งเสี่ยงต่อสุขภาพของคนในครอบครัว โดยเฉพาะเด็ก ผู้สูงอายุ และผู้ที่มีภูมิคุ้มกันต่ำ การเลือกใช้ เครื่องอบโอโซน Master Ozone คืออีกหนึ่งทางเลือกที่ช่วยปกป้องคนที่คุณรักอย่างมีประสิทธิภาพ ด้วยเทคโนโลยีการปล่อยโอโซนที่สามารถฆ่าเชื้อโรคในอากาศ กำจัดกลิ่นอับ และลดการสะสมของแบคทีเรียและไวรัสในบ้าน มั่นใจได้ว่าทุกลมหายใจของคุณและครอบครัวจะได้รับอากาศสะอาด สดชื่น และปลอดภัยยิ่งขึ้น

การใช้สเปรย์หรือสารเคมีในการกำจัดกลิ่นหรือฆ่าเชื้อบ่อย ๆ นอกจากจะเปลืองเงินในระยะยาวแล้ว ยังเสี่ยงต่อสุขภาพจากสารตกค้างและไอระเหยที่อาจสะสมในร่างกายโดยไม่รู้ตัว ทางเลือกที่ปลอดภัยและยั่งยืนกว่าคือการใช้เทคโนโลยี เช่น เครื่องโอโซนฆ่าเชื้อ ที่ช่วยขจัดปัญหากลิ่นและเชื้อโรคได้อย่างมีประสิทธิภาพโดยไม่ทิ้งสารเคมีตกค้างในสิ่งแวดล้อม

การต้องทำความสะอาดหรือพ่นน้ำยาบ่อย ๆ ไม่เพียงแต่สิ้นเปลืองเวลาและแรงงาน แต่ยังสร้างความไม่สะดวกในการใช้ชีวิตประจำวัน โดยเฉพาะในพื้นที่ขนาดใหญ่หรือใช้งานบ่อย การหาทางเลือกที่ช่วยลดภาระงานบ้าน เช่น เครื่องโอโซนฆ่าเชื้อ จึงเป็นอีกทางออกที่ช่วยประหยัดเวลาและลดการใช้แรงงานคนได้อย่างมีประสิทธิภาพ ในปัจจุบันมีตัวเลือกหลากหลาย ทั้งรุ่นครัวเรือนและเชิงพาณิชย์ โดยผู้บริโภคสามารถเปรียบเทียบ เครื่องอบโอโซนราคา ตามคุณสมบัติและขนาดที่เหมาะสมกับการใช้งานจริง เพื่อให้ได้ทั้งความคุ้มค่าและมาตรฐานด้านสุขอนามัยที่ตอบโจทย์ อีกทั้งยังมีนวัตกรรมใหม่อย่าง ozone fumigator ที่ถูกออกแบบมาเพื่อการฆ่าเชื้อและกำจัดกลิ่นในพื้นที่ขนาดใหญ่ เช่น โรงงาน สำนักงาน หรือสถานพยาบาล ทำให้สามารถดูแลความสะอาดได้อย่างทั่วถึงและมีประสิทธิภาพมากยิ่งขึ้น

ในยุคที่มาตรฐานความสะอาดเป็นสิ่งสำคัญ สถานประกอบการต่าง ๆ ไม่ว่าจะเป็นโรงแรม คลินิก หรือร้านอาหาร มักเผชิญกับความกังวลใจเรื่องความสะอาดภายในสถานที่ ไม่ว่าจะเป็นกลิ่นอับ กลิ่นบุหรี่ หรือเชื้อโรคที่มองไม่เห็น ปัญหาเหล่านี้อาจส่งผลกระทบต่อความพึงพอใจของลูกค้า และนำไปสู่การร้องเรียนหรือรีวิวในเชิงลบบนโลกออนไลน์ การรักษาความสะอาดและสุขอนามัยอย่างเข้มงวดจึงกลายเป็นหัวใจสำคัญในการสร้างความมั่นใจให้กับลูกค้า รวมถึงส่งเสริมภาพลักษณ์ที่ดีของธุรกิจในระยะยาว โดยเฉพาะในธุรกิจโรงแรม การเลือกใช้ เครื่องอบโอโซนโรงแรม ถือเป็นตัวช่วยสำคัญที่ช่วยกำจัดกลิ่นไม่พึงประสงค์และฆ่าเชื้อโรคภายในห้องพักได้อย่างมีประสิทธิภาพ ทำให้ผู้เข้าพักมั่นใจในความสะอาดและปลอดภัยของสถานที่มากยิ่งขึ้น
หนึ่งในตัวช่วยที่ได้รับความนิยมคือการใช้ best ozone generator ซึ่งสามารถผลิตก๊าซโอโซนเพื่อฆ่าเชื้อโรคและกำจัดกลิ่นไม่พึงประสงค์ได้อย่างมีประสิทธิภาพ การเลือกใช้ เครื่องozone สำหรับธุรกิจ จึงถือเป็นการลงทุนที่คุ้มค่าในการยกระดับมาตรฐานด้านสุขอนามัย
สำหรับผู้ประกอบการที่กำลังตัดสินใจว่าจะเลือก เครื่องผลิตโอโซนยี่ห้อไหนดี ควรพิจารณาจากประสิทธิภาพการทำงาน การรับรองมาตรฐานความปลอดภัย และบริการหลังการขาย เพื่อให้มั่นใจได้ว่าเครื่องที่เลือกจะตอบโจทย์ทั้งในด้านคุณภาพและการใช้งานจริง


ลงทุนในสุขภาพของคุณและครอบครัว ด้วย เครื่องโอโซนฆ่าเชื้อโรค ที่ช่วยทำให้อากาศปลอดภัยจากเชื้อโรคและกลิ่นไม่พึงประสงค์ สั่งซื้อวันนี้ เพื่อสัมผัสประสบการณ์อากาศบริสุทธิ์ที่แท้จริง! ไม่ว่าจะเป็นการ อบโอโซนห้อง เพื่อฆ่าเชื้อโรคและกำจัดกลิ่นในพื้นที่อยู่อาศัย หรือการใช้งานในเชิงพาณิชย์ เช่น โรงแรมและคลินิก ก็สามารถสร้างความมั่นใจด้านสุขอนามัยได้อย่างครบถ้วน นอกจากนี้ การเลือกใช้อุปกรณ์ ฆ่าเชื้อโอโซน ยังช่วยลดความเสี่ยงจากแบคทีเรีย เชื้อรา และไวรัสที่ลอยอยู่ในอากาศ
สำหรับผู้ที่มองหาทางออกที่มีประสิทธิภาพยิ่งขึ้น อุปกรณ์ ozone air purifier ถือเป็นตัวเลือกที่ตอบโจทย์ เพราะสามารถฟอกอากาศและฆ่าเชื้อไปพร้อมกัน ทำให้บ้านหรือสำนักงานของคุณสะอาด สดชื่น และปลอดภัยต่อสุขภาพในทุกๆ วัน

การฆ่าเชื้ออัจฉริยะด้วยการเปิดเพียงครั้งเดียว นวัตกรรมเทคโนโลยีที่ปลอดภัยยิ่งขึ้น
สัมผัสประสบการณ์การฆ่าเชื้อแบบอัจฉริยะ ด้วย เครื่องอบโอโซน Master Ozone Generator ที่ผสานนวัตกรรมเทคโนโลยีล้ำสมัย เพียงแค่เปิดใช้งานครั้งเดียว ก็สามารถกำจัดเชื้อโรค แบคทีเรีย และไวรัสในอากาศได้อย่างมีประสิทธิภาพ ช่วยให้คุณมั่นใจในความปลอดภัยยิ่งขึ้น ทุกพื้นที่สะอาด ปลอดภัย โดยไม่ต้องเสียเวลาเปิด-ปิดหรือควบคุมหลายขั้นตอน ตอบโจทย์ไลฟ์สไตล์ยุคใหม่ ที่เน้นความสะดวกและสุขอนามัยอย่างแท้จริง

เครื่องโอโซนฆ่าเชื้อ Ozone Generator เป็นเทคโนโลยีที่ได้รับความไว้วางใจจากบริษัทและองค์กรชั้นนำหลากหลายวงการ ไม่ว่าจะเป็นโรงแรม รีสอร์ท โรงพยาบาล สำนักงาน รวมถึงโรงงานอุตสาหกรรม เนื่องจากสามารถช่วยกำจัดเชื้อโรค กลิ่นไม่พึงประสงค์ และสร้างมาตรฐานความสะอาดระดับมืออาชีพได้อย่างมีประสิทธิภาพ ตอบโจทย์ความต้องการด้านสุขอนามัยในยุคปัจจุบัน พร้อมเสริมภาพลักษณ์องค์กรที่ใส่ใจสุขภาพและความปลอดภัยของลูกค้าและพนักงานอย่างแท้จริง นอกจากนี้ การใช้งานในรูปแบบ อบโอโซนห้อง ยังช่วยยกระดับคุณภาพอากาศภายในพื้นที่อยู่อาศัยหรือสถานที่สาธารณะได้อย่างครอบคลุม ไม่ว่าจะเป็นห้องพักในโรงแรมหรือออฟฟิศที่ต้องการความสะอาดสูงสุด
ด้วยคุณสมบัติในการ ฆ่าเชื้อโอโซน เครื่องประเภทนี้จึงสามารถยับยั้งไวรัส แบคทีเรีย และเชื้อราได้อย่างมีประสิทธิภาพสูง ลดความเสี่ยงจากโรคติดต่อและสร้างสภาพแวดล้อมที่ปลอดภัยสำหรับทุกคน
และสำหรับผู้ที่ต้องการโซลูชันครบวงจร อุปกรณ์ประเภท ozone air purifier ก็เป็นอีกหนึ่งทางเลือกที่ช่วยทั้งฟอกอากาศและฆ่าเชื้อไปพร้อมกัน เหมาะกับทั้งบ้านเรือนและธุรกิจที่ให้ความสำคัญกับมาตรฐานสุขอนามัย


ผ่านการทดสอบตามมาตรฐาน ISO และรับรองโดย Intertek – Total Quality. Assured. ลดปริมาณเชื้อโรคได้สูงสุด 10 เท่า ยืนยันคุณภาพและประสิทธิภาพในการฆ่าเชื้ออย่างปลอดภัยและน่าเชื่อถือ สำหรับผู้ที่กำลังมองหา เครื่องผลิตโอโซนยี่ห้อไหนดี การเลือกอุปกรณ์ที่ผ่านการรับรองมาตรฐานสากลเช่นนี้ ถือเป็นตัวเลือกที่มั่นใจได้ทั้งด้านความปลอดภัย ประสิทธิภาพ และการใช้งานจริง เหมาะสำหรับทั้งครัวเรือนและองค์กรที่ต้องการยกระดับมาตรฐานสุขอนามัยอย่างแท้จริง






สร้างมาตรฐานความสะอาดระดับมืออาชีพด้วย เครื่องโอโซนฆ่าเชื้อ Master Ozone Generator สุดยอดเทคโนโลยี เครื่องอบโอโซนอุตสาหกรรม ที่ตอบโจทย์องค์กรยุคใหม่ ไม่ว่าจะเป็นโรงแรม รีสอร์ท โรงพยาบาล สำนักงาน รวมถึงโรงงานอุตสาหกรรม เนื่องจากสามารถช่วยกำจัดเชื้อโรค กลิ่นไม่พึงประสงค์ และสร้างมาตรฐานความสะอาดระดับมืออาชีพได้อย่างมีประสิทธิภาพ ตอบโจทย์ความต้องการด้านสุขอนามัยในยุคปัจจุบัน พร้อมเสริมภาพลักษณ์องค์กรที่ใส่ใจสุขภาพและความปลอดภัยของลูกค้าและพนักงานอย่างแท้จริง

รับรองผลทดสอบประสิทธิภาพ โดย Intertek ประเทศอังกฤษ
เครื่องอบโอโซน Master Ozone Generator
ได้รับการทดสอบและรับรองประสิทธิภาพการฆ่าเชื้อจากสถาบันระดับโลก “Intertek” ประเทศอังกฤษ ซึ่งเป็นเจ้าเดียวในประเทศไทยที่ผ่านมาตรฐานนี้
การันตี! ฆ่าเชื้อโรคได้มากกว่า 10 เท่า ภายในเวลาเพียง 30 นาที
มั่นใจในประสิทธิภาพการกำจัดเชื้อโรคและไวรัสต่างๆ ได้อย่างรวดเร็วและปลอดภัย เพิ่มความมั่นใจให้กับผู้ใช้ทั้งในบ้านและในธุรกิจ

ใบรับรองผลทดสอบ เครื่องโอโซนฆ่าเชื้อ Master Ozone
มั่นใจในคุณภาพและความปลอดภัย ด้วยการรับประกันสินค้าที่ครอบคลุม พร้อมใบรับรองผลทดสอบจากสถาบันระดับสากล Intertek ประเทศอังกฤษ การันตีประสิทธิภาพการฆ่าเชื้อและกำจัดกลิ่น ให้คุณใช้งานอย่างมั่นใจในทุกสถานการณ์


ผลทดสอบจากหน้างานจริง สามารถฆ่าเชื้อได้ถึง 99.99%

สรุปเหตุผลที่คุณควรเลือก เครื่องโอโซนฆ่าเชื้อ Master Ozone
เครื่องกำเนิดโอโซน Master Ozone Generator เป็นคำตอบสำหรับการฆ่าเชื้อและกำจัดกลิ่นในทุกพื้นที่ ด้วยฟังก์ชันที่หลากหลาย ดีไซน์กะทัดรัด และประสิทธิภาพที่เหนือกว่า มั่นใจได้ว่า เครื่องผลิตโอโซน จะช่วยยกระดับคุณภาพอากาศและสุขภาพของคุณได้อย่างแท้จริง
หากคุณกำลังมองหาคำตอบว่า เครื่องอบโอโซนยี่ห้อไหนดี ที่ให้ผลลัพธ์ชัดเจน ปลอดภัย และคุ้มค่าในระยะยาว Master Ozone คือหนึ่งในตัวเลือกที่ได้รับความไว้วางใจจากทั้งผู้ใช้งานทั่วไปและองค์กรระดับมืออาชีพ ด้วยประสิทธิภาพในการฆ่าเชื้อไวรัส แบคทีเรีย และเชื้อรา พร้อมกำจัดกลิ่นไม่พึงประสงค์ได้อย่างล้ำลึก โดยไม่ทิ้งสารตกค้าง
ด้วยความหลากหลายของรุ่นสินค้า Master Ozone จึงตอบโจทย์ทุกความต้องการ ตั้งแต่ระดับบ้านพักอาศัย คลินิก ไปจนถึงการเป็น เครื่องอบโอโซนอุตสาหกรรม ที่ทรงพลังสำหรับโรงงานและโรงแรมขนาดใหญ่ หากคุณยังไม่แน่ใจว่าจะเลือก เครื่องอบโอโซนยี่ห้อไหนดี ที่ใช้งานง่ายและมีมาตรฐานรองรับ Master Ozone คือคำตอบที่ช่วยให้คุณมั่นใจในสุขอนามัยได้อย่างเต็มเปี่ยม
สั่งซื้อตอนนี้ พร้อมโปรโมชั่นพิเศษ! ติดต่อเราเพื่อรับคำแนะนำและข้อมูลเพิ่มเติม!

.




หากคุณกำลังมองหาบริการที่ช่วยดูแลสุขอนามัยทั้งในบ้าน รถยนต์ หรือสถานประกอบการ บริการ อบโอโซน ราคา คุ้มค่าและได้มาตรฐานจากเรา คือคำตอบที่เหมาะสมที่สุด เราใช้เครื่องโอโซนที่ผ่านการรับรอง และทีมงานที่มีประสบการณ์ตรง เพื่อให้มั่นใจได้ว่าทุกพื้นที่ของคุณจะสะอาด ปลอดเชื้อ และไร้กลิ่นไม่พึงประสงค์
ไม่ว่าคุณจะต้องการบริการ รับอบโอโซน ในบ้าน คอนโด โรงแรม โรงงาน หรือสถานที่สาธารณะ เราพร้อมให้บริการอย่างครบวงจร มาตรฐานเดียวกับระดับสากล เพื่อช่วยสร้างสภาพแวดล้อมที่ปลอดภัยและน่าอยู่มากยิ่งขึ้น
สอบถามฟรี! ยินดีแนะนำก่อนตัดสินใจ